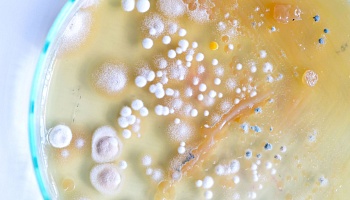

Вторник, 28.04.2026
Пятница, 17.04.2026
Понедельник, 06.04.2026
Пятница, 03.04.2026
Четверг, 02.04.2026
Среда, 01.04.2026
Вторник, 24.03.2026
Пятница, 20.03.2026
Среда, 11.03.2026
Воскресенье, 08.03.2026
Пятница, 06.03.2026
Среда, 25.02.2026
Пятница, 20.02.2026
Пятница, 20.02.2026
Среда, 11.02.2026
Воскресенье, 08.02.2026
Среда, 04.02.2026
Среда, 28.01.2026
Понедельник, 12.01.2026
Пятница, 09.01.2026
Вторник, 06.01.2026
Пятница, 19.12.2025
Четверг, 18.12.2025
Четверг, 18.12.2025
Вторник, 16.12.2025
Пятница, 05.12.2025
Среда, 03.12.2025
Пятница, 28.11.2025
Вторник, 25.11.2025
Пятница, 21.11.2025
Пятница, 07.11.2025
Суббота, 01.11.2025
Понедельник, 29.09.2025
Понедельник, 29.09.2025
Пятница, 26.09.2025
Пятница, 26.09.2025
Среда, 24.09.2025
Понедельник, 22.09.2025
Понедельник, 15.09.2025
Вторник, 09.09.2025
Четверг, 28.08.2025
Четверг, 07.08.2025
Пятница, 25.07.2025
Четверг, 24.07.2025
Среда, 23.07.2025
Воскресенье, 20.07.2025
Пятница, 18.07.2025
Пятница, 20.06.2025
Четверг, 19.06.2025
Понедельник, 16.06.2025
Воскресенье, 15.06.2025
Четверг, 05.06.2025
Четверг, 05.06.2025
Понедельник, 02.06.2025
Четверг, 29.05.2025
Четверг, 29.05.2025
Понедельник, 26.05.2025
Четверг, 22.05.2025
Четверг, 15.05.2025
Среда, 30.04.2025
Вторник, 15.04.2025
Пятница, 11.04.2025
Пятница, 11.04.2025
Пятница, 11.04.2025
Среда, 09.04.2025
Вторник, 08.04.2025
Четверг, 13.03.2025
Вторник, 11.03.2025
Среда, 26.02.2025
Среда, 26.02.2025
Понедельник, 10.02.2025
Понедельник, 20.01.2025
Понедельник, 13.01.2025
Понедельник, 16.12.2024
Понедельник, 09.12.2024
Пятница, 06.12.2024
Среда, 04.12.2024
Воскресенье, 01.12.2024
Вторник, 19.11.2024
Пятница, 01.11.2024
Вторник, 08.10.2024
Среда, 02.10.2024
Понедельник, 16.09.2024
Вторник, 10.09.2024
Среда, 28.08.2024
Вторник, 09.07.2024
Четверг, 04.07.2024
Четверг, 20.06.2024
Пятница, 14.06.2024
Четверг, 13.06.2024
Вторник, 28.05.2024
Воскресенье, 26.05.2024
Пятница, 24.05.2024
Среда, 22.05.2024
Вторник, 21.05.2024
Вторник, 21.05.2024
Четверг, 16.05.2024
Среда, 15.05.2024
Среда, 15.05.2024
Среда, 10.04.2024
Четверг, 04.04.2024
Вторник, 26.03.2024
Понедельник, 25.03.2024
Среда, 13.03.2024
Среда, 06.03.2024
Понедельник, 04.03.2024
Вторник, 20.02.2024
Суббота, 17.02.2024
Четверг, 15.02.2024
Понедельник, 12.02.2024
Четверг, 08.02.2024
Понедельник, 05.02.2024
Понедельник, 05.02.2024
Вторник, 19.12.2023
Пятница, 08.12.2023
Вторник, 05.12.2023
Понедельник, 04.12.2023
Понедельник, 04.12.2023
Четверг, 30.11.2023
Среда, 29.11.2023
Пятница, 24.11.2023
Пятница, 24.11.2023
Среда, 22.11.2023
Суббота, 18.11.2023
Среда, 15.11.2023
Понедельник, 13.11.2023
Среда, 08.11.2023
Вторник, 07.11.2023
Вторник, 07.11.2023
Вторник, 31.10.2023
Четверг, 12.10.2023
Пятница, 06.10.2023
Пятница, 22.09.2023
Среда, 20.09.2023
Вторник, 12.09.2023
Вторник, 05.09.2023
Пятница, 11.08.2023
Среда, 26.07.2023
Пятница, 14.07.2023
Четверг, 13.07.2023
Четверг, 29.06.2023
Четверг, 29.06.2023
Понедельник, 26.06.2023
Понедельник, 26.06.2023
Вторник, 20.06.2023
Четверг, 08.06.2023
Четверг, 08.06.2023
Четверг, 01.06.2023
Четверг, 01.06.2023
Среда, 31.05.2023
Понедельник, 29.05.2023
Четверг, 25.05.2023
Пятница, 19.05.2023
Понедельник, 15.05.2023
Пятница, 12.05.2023
Четверг, 11.05.2023
Пятница, 05.05.2023
Вторник, 02.05.2023
Четверг, 27.04.2023
Пятница, 31.03.2023
Вторник, 21.03.2023
Среда, 01.02.2023
Среда, 25.01.2023
Пятница, 30.12.2022
Понедельник, 26.12.2022
Пятница, 23.12.2022
Среда, 14.12.2022
Пятница, 09.12.2022
Пятница, 02.12.2022
Пятница, 02.12.2022
Вторник, 29.11.2022
Пятница, 18.11.2022
Среда, 09.11.2022
Вторник, 08.11.2022
Понедельник, 31.10.2022
Четверг, 27.10.2022
Среда, 26.10.2022
Пятница, 21.10.2022
Среда, 19.10.2022
Вторник, 04.10.2022
Понедельник, 26.09.2022
Среда, 21.09.2022
Четверг, 15.09.2022
Понедельник, 12.09.2022
Пятница, 09.09.2022
Вторник, 06.09.2022
Вторник, 19.07.2022
Среда, 13.07.2022
Суббота, 09.07.2022
Четверг, 07.07.2022
Среда, 29.06.2022
Понедельник, 27.06.2022
Вторник, 21.06.2022
Пятница, 17.06.2022
Четверг, 16.06.2022
Пятница, 10.06.2022
Понедельник, 06.06.2022
Пятница, 03.06.2022
Четверг, 02.06.2022
Суббота, 30.04.2022
Суббота, 16.04.2022
Пятница, 08.04.2022
Понедельник, 28.03.2022
Четверг, 17.03.2022
Пятница, 04.03.2022
Понедельник, 21.02.2022
Четверг, 10.02.2022
Среда, 09.02.2022
Вторник, 01.02.2022
Среда, 26.01.2022
Понедельник, 24.01.2022
Пятница, 14.01.2022
Четверг, 23.12.2021
Вторник, 21.12.2021
Пятница, 17.12.2021
Пятница, 17.12.2021
Воскресенье, 12.12.2021
Вторник, 07.12.2021
Понедельник, 15.11.2021
Пятница, 05.11.2021
Пятница, 29.10.2021
Четверг, 28.10.2021
Вторник, 26.10.2021
Четверг, 21.10.2021
Четверг, 14.10.2021
Вторник, 12.10.2021
Воскресенье, 10.10.2021
Четверг, 30.09.2021
Четверг, 23.09.2021
Вторник, 21.09.2021
Понедельник, 20.09.2021
Четверг, 16.09.2021
Среда, 15.09.2021
Вторник, 14.09.2021
Вторник, 14.09.2021
Пятница, 10.09.2021
Среда, 18.08.2021
Вторник, 10.08.2021
Среда, 04.08.2021
Пятница, 23.07.2021
Понедельник, 19.07.2021
Понедельник, 19.07.2021
Вторник, 29.06.2021
Четверг, 03.06.2021
Среда, 19.05.2021
Понедельник, 17.05.2021
Среда, 12.05.2021
Понедельник, 10.05.2021
Воскресенье, 09.05.2021
Четверг, 06.05.2021
Среда, 21.04.2021
Понедельник, 19.04.2021
Среда, 14.04.2021
Понедельник, 12.04.2021
Четверг, 25.03.2021
Вторник, 23.03.2021
Понедельник, 15.03.2021
Пятница, 12.03.2021
Среда, 10.03.2021
Вторник, 02.03.2021
Понедельник, 01.03.2021
Среда, 24.02.2021
Четверг, 11.02.2021
Понедельник, 08.02.2021
Четверг, 04.02.2021
Вторник, 02.02.2021
Понедельник, 01.02.2021
Понедельник, 25.01.2021
Пятница, 22.01.2021
Четверг, 21.01.2021
Среда, 20.01.2021
Вторник, 19.01.2021
Понедельник, 18.01.2021
Воскресенье, 17.01.2021
Среда, 13.01.2021
Среда, 30.12.2020
Вторник, 29.12.2020
Пятница, 25.12.2020
Четверг, 24.12.2020
Вторник, 22.12.2020
Пятница, 18.12.2020
Среда, 16.12.2020
Среда, 16.12.2020
Вторник, 15.12.2020
Понедельник, 14.12.2020
Понедельник, 07.12.2020
Понедельник, 07.12.2020
Пятница, 04.12.2020
Среда, 18.11.2020
Четверг, 12.11.2020
Четверг, 12.11.2020
Четверг, 12.11.2020
Вторник, 10.11.2020
Вторник, 10.11.2020
Вторник, 10.11.2020
Пятница, 06.11.2020
Вторник, 03.11.2020
Вторник, 03.11.2020
Пятница, 30.10.2020
Среда, 28.10.2020
Понедельник, 26.10.2020
Понедельник, 26.10.2020
Понедельник, 26.10.2020
Четверг, 22.10.2020
Четверг, 22.10.2020
Пятница, 16.10.2020
Пятница, 16.10.2020
Пятница, 09.10.2020
Четверг, 08.10.2020
Пятница, 02.10.2020
Четверг, 01.10.2020
Вторник, 29.09.2020
Четверг, 24.09.2020
Среда, 16.09.2020
Вторник, 15.09.2020
Вторник, 15.09.2020
Среда, 09.09.2020
Среда, 02.09.2020
Вторник, 01.09.2020
Понедельник, 31.08.2020
Среда, 26.08.2020
Вторник, 25.08.2020
Вторник, 25.08.2020
Четверг, 20.08.2020
Четверг, 20.08.2020
Четверг, 20.08.2020
Вторник, 18.08.2020
Понедельник, 17.08.2020
Пятница, 14.08.2020
Четверг, 06.08.2020
Четверг, 06.08.2020
Среда, 05.08.2020
Четверг, 23.07.2020
Четверг, 23.07.2020
Среда, 08.07.2020
Вторник, 23.06.2020
Понедельник, 08.06.2020
Четверг, 28.05.2020
Пятница, 22.05.2020
Вторник, 19.05.2020
Среда, 29.04.2020
Пятница, 24.04.2020
Понедельник, 20.04.2020
Вторник, 14.04.2020
Вторник, 14.04.2020
Пятница, 10.04.2020
Среда, 08.04.2020
Четверг, 26.03.2020
Понедельник, 23.03.2020
Понедельник, 23.03.2020
Среда, 18.03.2020
Среда, 11.03.2020
Пятница, 06.03.2020
Понедельник, 17.02.2020
Понедельник, 10.02.2020
Суббота, 08.02.2020
Пятница, 07.02.2020
Четверг, 06.02.2020
Понедельник, 03.02.2020
Понедельник, 03.02.2020
Вторник, 28.01.2020
Вторник, 28.01.2020
Вторник, 28.01.2020
Четверг, 23.01.2020
Пятница, 27.12.2019
Понедельник, 23.12.2019
Понедельник, 23.12.2019
Понедельник, 23.12.2019
Среда, 27.11.2019
Пятница, 15.11.2019
Четверг, 14.11.2019
Пятница, 01.11.2019
Пятница, 18.10.2019
Пятница, 11.10.2019
Пятница, 04.10.2019
Пятница, 04.10.2019
Пятница, 04.10.2019
Пятница, 04.10.2019
Пятница, 04.10.2019
Пятница, 04.10.2019
Пятница, 04.10.2019
Среда, 02.10.2019
Среда, 25.09.2019
Среда, 25.09.2019
Среда, 18.09.2019
Четверг, 12.09.2019
Среда, 11.09.2019
Четверг, 05.09.2019
Вторник, 03.09.2019
Понедельник, 02.09.2019
Понедельник, 02.09.2019
Пятница, 30.08.2019
Пятница, 30.08.2019
Четверг, 29.08.2019
Четверг, 29.08.2019
Понедельник, 19.08.2019
Понедельник, 19.08.2019
Понедельник, 19.08.2019
Вторник, 13.08.2019
Понедельник, 12.08.2019
Понедельник, 05.08.2019
Понедельник, 29.07.2019
Четверг, 25.07.2019
Вторник, 23.07.2019
Пятница, 19.07.2019
Понедельник, 15.07.2019
Понедельник, 08.07.2019
Понедельник, 17.06.2019
Понедельник, 17.06.2019
Пятница, 14.06.2019
Вторник, 11.06.2019
Вторник, 11.06.2019
Понедельник, 10.06.2019
Понедельник, 03.06.2019
Понедельник, 03.06.2019
Пятница, 24.05.2019
Понедельник, 20.05.2019
Понедельник, 20.05.2019
Понедельник, 20.05.2019
Суббота, 18.05.2019
Пятница, 17.05.2019
Пятница, 17.05.2019
Четверг, 16.05.2019
Вторник, 14.05.2019
Понедельник, 13.05.2019
Понедельник, 06.05.2019
Понедельник, 06.05.2019
Понедельник, 06.05.2019
Среда, 24.04.2019
Вторник, 23.04.2019
Вторник, 23.04.2019
Понедельник, 22.04.2019
Среда, 17.04.2019
Среда, 17.04.2019
Среда, 17.04.2019
Среда, 10.04.2019
Понедельник, 08.04.2019
Понедельник, 08.04.2019
Понедельник, 08.04.2019
Пятница, 29.03.2019
Четверг, 28.03.2019
Суббота, 23.03.2019
Вторник, 19.02.2019
Понедельник, 18.02.2019
Среда, 13.02.2019
Пятница, 08.02.2019
Четверг, 07.02.2019
Среда, 06.02.2019
Вторник, 05.02.2019
Пятница, 01.02.2019